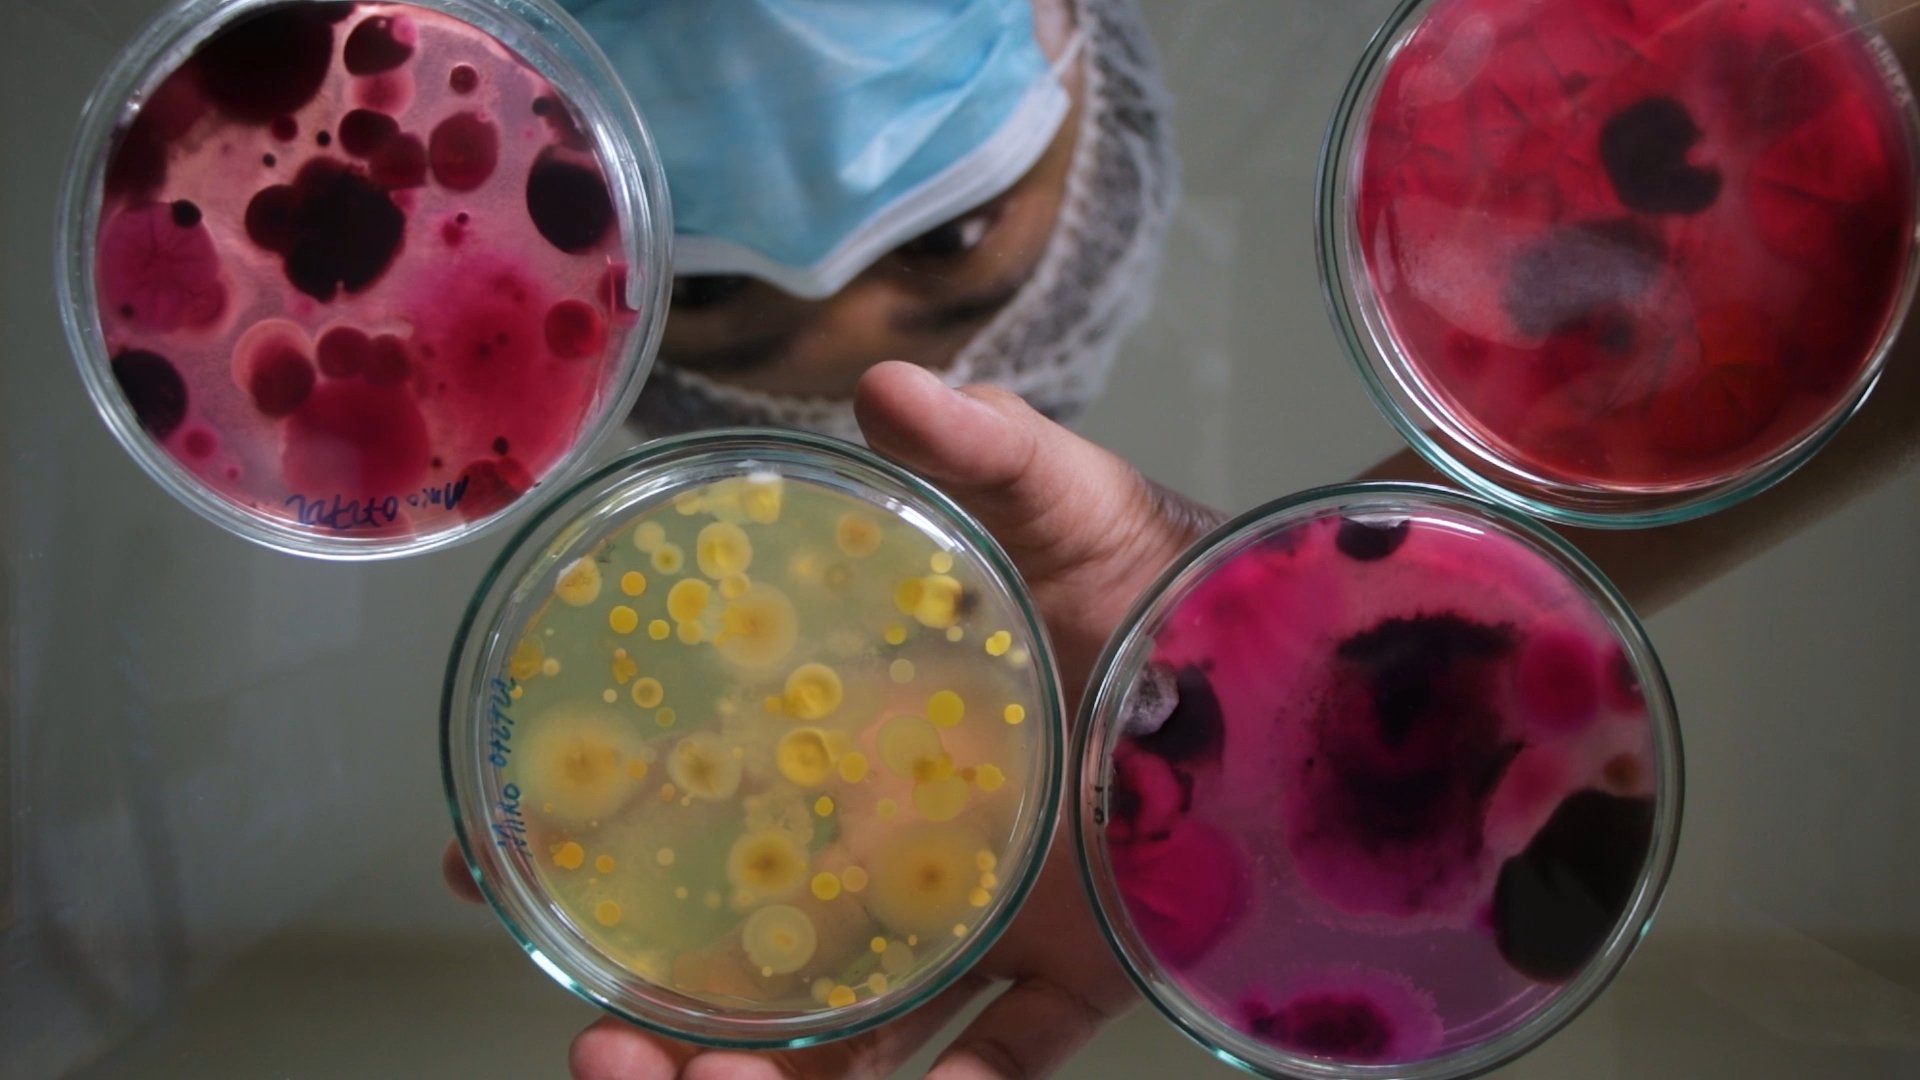

Pabili PO!



[ premise ]
A couple’s quest to look for missing ingredients takes them to a sari-sari store that offers more than what they’re looking for.
[ vision ]
Couples planning their wedding nowadays get bombarded with usual ads about venues placed on social media. Pabili Po! is meant to break this cycle through an unconventional hook.


unseen spaces











[ goal ]
Create a wedding venue advertisement for Alta Veranda de Tibig following the theme unseen spaces & overlooked moments.
[ vision ]
Intimacy is an overlooked aspect in the events place industry. I wanted to show the private moments before and after the wedding – selling the unseen.


maryosep

[ logline ]
Gracing humanity with his presence in an afternoon drinking session with His neighbors. Their gathering let Hesus witness the whole of their humanity, even His own.
[ vision ]
I wanted to create a film that would tie it all together. A play on politically and socially accepted imagery. This is a statement against these so called "religions" and the ongoing abuse of foreigners in the Philippines.


DAYUHAN

[ logline ]
A surgery to finally fit in bears a heavy risk, pushing an alien immigrant to make last-minute precautionary measures on the day of his surgery.
[ vision ]
Racial discrimination is inevitable. This film is an alternative take on what the future has in store for migrants – the minority who experience physical discrimination, emotional trauma, and societal pressure.


lusaw: exploring
urban agriculture
[ docu ]

[ logline ]
Two filmmakers take on a journey to explore the intricacies of Philippine agriculture, seeking for possible solutions as they figure out the factors causing the crisis.
[ vision ]
A reminder of what’s probably the most overlooked issue the country has been facing for decades – food security.



[ corporate overview ]
coca-cola
[ goal ]
Create a capability video featuring the Central Laboratory of Coca-Cola Beverages Philippines.
[ vision ]
Corporate videos should not stay away from eye-candy visuals. Taking inspiration from Breaking Bad, unique perspective shots were the priority.